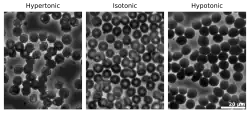

Cytolyse

La cytolyse (du grec cyto : la cellule et lyse : la destruction) est la dissolution ou destruction des cellules.
On la différencie de deux types de destruction de cellules[1] :
Fonctionnement
La cytolyse, ou lyse osmotique, se produit lorsqu'une cellule éclate en raison d'un déséquilibre osmotique qui provoque la diffusion d'un excès d'eau dans la cellule. L'eau peut pénétrer dans la cellule par diffusion à travers la membrane cellulaire ou par des canaux membranaires sélectifs appelés aquaporines, qui facilitent grandement l'écoulement de l'eau[2]. Il se produit dans un environnement hypotonique, où l'eau pénètre dans la cellule par osmose et fait augmenter son volume au point où le volume dépasse la capacité de la membrane et la cellule éclate. La présence d'une paroi cellulaire empêche la membrane d'éclater, de sorte que la cytolyse ne se produit que dans les cellules animales et protozoaires qui n'ont pas de parois cellulaires. Le processus inverse est la plasmolyse.
La prévention
Différentes cellules et organismes adaptent différentes manières d'empêcher la cytolyse de se produire. Par exemple, la paramécie utilise une vacuole contractile, qui pompe rapidement l'excès d'eau pour empêcher l'accumulation d'eau et la lyse ultérieure[3].
Articles connexes
Notes et références
Références
- ↑ docThom, « Définition de "Cytolyse" », sur Dictionnaire médical (consulté le )
- ↑ Bruce Alberts, Essential Cell Biology, New York, NY, 4th, (ISBN 978-0-8153-4454-4), p. 388
- ↑ Neil A. Campbell, Jane B. Reece, Lisa A. Urry, Michael L. Cain, Wasserman, Minorsky et Jackson, Biology, 9th, (ISBN 9780321558237, lire en ligne
 ), 134
), 134
Bibliographie
- Jesse Francis McClendon, Physical Chemistry of Vital Phenomena, Original from the University of California, Princeton University Press, (lire en ligne), 240 pages :
« Cytolysis -wikipedia. »
- Portail de la biologie cellulaire et moléculaire